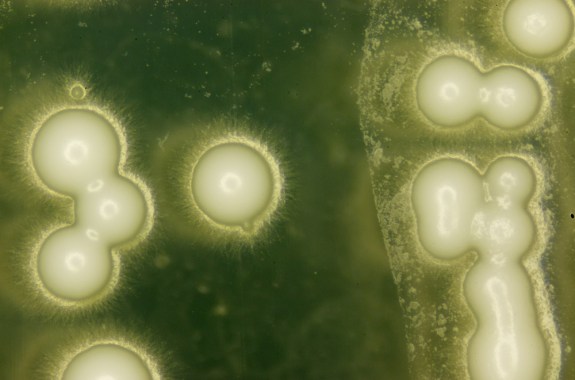
Synthetic Yeast, Fake Science News, and the Tully Monster

Christie Taylor was a producer for Science Friday. Her days involved diligent research, too many phone calls for an introvert, and asking scientists if they have any audio of that narwhal heartbeat. She also coordinates SciFri’s coverage of science and the arts (“sciarts”).
During her undergraduate at the University of Wisconsin-Madison, Christie was almost a biology major but took a chance turn down the path of thing-explaining and realized it was the only thing she wanted to do. Since then, she’s worked as a print and online reporter, technical writer, and a science writer for a university press office.
She takes extra joy in writing interview questions about space exploration, creative research methods, and the intersection of science and society.
17:19
Why Are We Here? Physics Has Answers
Physicist Lawrence Krauss on the substance of the universe, the Higgs Boson, and how we know what we know.
7:31
Synthetic Yeast, Fake Science News, and the Tully Monster
Researchers have now synthesized over a third of the yeast genome.
17:21
The Invisible Humans Who Sanitize the Internet
Content moderators work behind the scenes to keep graphic content off your feed. But they still have to view it.
16:17
A Thumb Drive Made of Genes?
We keep talking about storing our data in DNA. How soon will it happen?
17:19
Has California’s Five-Year Drought Washed Away?
Predicting rain, snow, and water supply in the warming West.
31:55
Computer Hacks of the Future, and How to Prevent Them
As self-driving cars and other artificial intelligence advance, how safe will we be from A.I. hacks and attacks?
4:33
A Mood Ring for Your Wrist
A new wearable aims to help people who feel socially awkward interpret others’ emotions.
16:10
How Humans Might Really Colonize The Solar System
The minds behind the “The Expanse” chat about space flight, space politics, and how they keep the show feeling real.
25:14
From the Arctic to Enceladus: A Celebration of Unusual Ice
Researchers who study icy places have discovered uncanny phenomena.
8:29
An Earthly Origin for Moon Oxygen?
Why some of the oxygen in the moon’s soil may have come from our ozone layer. Plus, is the moon more ancient than we thought?